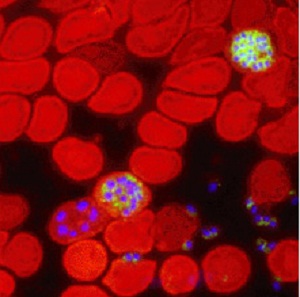

Theo tờ Science News của Mỹ, hiện nay, các nhà khoa học thế giới, đặc biệt là của Anh và Mỹ đang bắt tay vào thực hiện một nghiên cứu tham vọng nhằm chế ngự những căn bệnh nan y do loài muỗi gây ra, nhất là sốt xuất huyết và sốt rét bằng cách tạo ra những dòng muỗi mới, gọi là muỗi chuyển gen.
Muỗi chuyển gen (Genetically Modified Mosquito hay Genetically Altered Mosquito), gọi tắt là muỗi GMM, có khả năng kháng lại ký sinh trùng gây bệnh sốt xuất huyết và sốt rét, được thả vào môi trường tự nhiên để nó “thuần hóa” đồng loại và được coi là “côn trùng cạnh tranh sinh học”, chấm dứt sự lan truyền ký sinh trùng và virut gây bệnh, tạo ra thế hệ muỗi an toàn. Dự án dùng siêu muỗi GMM để tiêu diệt mầm bệnh sốt rét, sốt xuất huyết được các nhà khoa học thai nghén từ cuối thập niên 80 ở thế kỷ trước, nhất là khi dịch sốt xuất huyết và sốt rét lan truyền mạnh ở các quốc gia phát triển châu Á, châu Phi, Trung và Nam Mỹ. Dự án được sự đồng thuận cao của cộng đồng khoa học thế giới, trong đó Quỹ Bill & Melinda Gates của gia đình tỷ phú người Mỹ Bill Gates tài trợ nguồn vốn 38 triệu USD. Mục tiêu của dự án là biến loài muỗi đực Aedes aegypti chuyên lan truyền sốt xuất huyết và muỗi Anopheles stephensi gây bệnh sốt rét thành muỗi chuyển gen, sau đó thả vào môi trường tự nhiên. Loài muỗi mới này vẫn có thể kết đôi, giao phối nhưng không thể sinh sản được, tất cả các trứng thụ tinh đều chết trước khi phát triển đầy đủ.
|
Ký sinh trùng Plasmodium gây bệnh sốt rét |
Trên tạp chí Public Library of Science Pathogens của Mỹ số ra gần đây đã đăng tải nghiên cứu của nhóm chuyên gia ở Đại học Arizona (UOA) cho biết, đây là lần đầu tiên con người lai tạo thành công giống muỗi GMM thông qua việc sử dụng cơ chế miễn dịch hoàn toàn với ký sinh trùng gây bệnh, ký sinh trùng có tên là Plasmodium hay còn gọi là máu có chứa ký sinh trùng Plasmodium. Theo ông Michael Riehle, người đứng đầu nhóm nghiên cứu của UOA, để tạo ra loài muỗi GMM, các nhà khoa học đã sử dụng kỹ thuật sinh học phân tử tạo ra một mẫu thông tin di truyền có khả năng tự nó cài vào hệ gen của muỗi. Cấu trúc này sau đó được tiêm vào trứng muỗi để tạo ra một dòng muỗi mới mang thông tin di truyền đã được chuyển đổi và truyền tiếp sang cho thế hệ con cái của chúng. Trong thí nghiệm nói trên của UOA, các nhà khoa học đã sử dụng muỗi Anopheles stephensi, một loài muỗi chuyên gây lan truyền bệnh sốt rét ở vùng Đông Nam Á, Ấn Độ. Trong quá trình nghiên cứu, các nhà khoa học trọng tâm đến cấu trúc sinh hóa bên trong các di truyền đóng vai trò như là một công tắc chuyển mạch phân tử để kiểm soát các chức năng chuyển hóa cực kỳ phức tạp bên trong tế bào. Cấu trúc di truyền đóng vai trò như một công tắc chuyển mạch, luôn luôn đặt ở vị trí “mở” (on) để kích hoạt liên tục một enzym tín hiệu có tên là Akt. Để kiểm chứng, các nhà khoa học đã cho muỗi GMM hút máu đã nhiễm ký sinh trùng sốt rét và phát hiện thấy các ký sinh trùng Plasmodium không còn gây nhiễm sang động vật khác nữa.
Thông thường, chỉ có muỗi cái hút máu để giúp nó sinh sản và nuôi dưỡng trứng. Khi đốt người hay động vật bị bệnh, muỗi sẽ tiêu hóa cả ký sinh trùng gây bệnh. Khi các ký sinh trùng Plasmodium có trong hệ thống tiêu hóa của muỗi, tự nó sẽ tìm cách phát triển và trong vòng từ 10 đến 12 ngày, hàng nghìn ký sinh trùng Plasmodium mới gọi là Sporozoite (thoa trùng) sẽ ra đời. Đây là mầm bên trong kén hợp tử và sau khi nở, các thoa trùng này sống trong tuyến nước bọt của muỗi, chờ thời cơ khi muỗi đốt để thâm nhập vào dòng máu của những người khỏe mạnh. Mỗi lần đốt, muỗi truyền khoảng 40 thoa trùng nhưng chỉ gây nhiễm một người hay một con vật. Hiện nay, trên thế giới có rất nhiều loại ký sinh trùng Plasmodium gây bệnh, tất cả các Plasmodium đều là vi sinh vật dạng đơn bào sống trong dòng máu động vật chủ, nhưng nhờ muỗi, nó có thể lan truyền cho những vật thể khỏe mạnh trong thời gian rất nhanh.
 |
6.000 con muỗi chuyển gen được thả vào môi trường ở Malaysia để thử nghiệm. |
Cùng với các chuyên gia ở UOA, một nghiên cứu khác của chuyên gia ở Đại học John Hopkins Bloomberg cũng mang lại những kết quả tương tự, tạo ra những con muỗi chuyển gen có sức sống vượt trội so với muỗi hoang đồng loại và chịu được các loại ký sinh trùng sốt rét Plasmodium và các loại ký sinh trùng khác có tên là Plasmodium berghei, dòng ký sinh trùng sốt rét gây nhiễm trên chuột. Trong quá trình tạo muỗi chuyển gen, người ta đã cấy một gen có tên là OX513 chiết xuất từ san hô vào hệ ADN của muỗi.
Nghiên cứu tạo giống muỗi chuyển gen được xem là bước đột phá trong cuộc chiến chống bệnh sốt rét và sốt xuất huyết của nhân loại những năm đầu thế kỷ 21. Nó có ý nghĩa to lớn trong lĩnh vực phòng bệnh vì theo số liệu của Tổ chức Y tế Thế giới (WHO), hằng năm trên thế giới có khoảng 250 triệu người bị bệnh sốt rét do một trong số 25 loài muỗi Anopheles gây ra và còn muỗi Aedes aegypti sống nhiều ở những vùng khí hậu lạnh, phát triển nhanh trong môi trường đô thị lại là thủ phạm gây lan truyền ký sinh trùng gây bệnh sốt xuất huyết. Dự án tạo muỗi GMM thành công và đầu tháng 2/2011, các nhà khoa học đã thả 6.000 con muỗi GMM vào môi trường để thử nghiệm, đối phó với căn bệnh sốt xuất huyết đang có nguy cơ hoành hành mạnh tại quốc gia này. Tuy thành công bước đầu nhưng hiện nay các nhà khoa học vẫn đang tiếp tục giải quyết những rào cản tồn tại, đặc biệt là trong cơ chế di truyền để không chỉ tăng nhanh số lượng muỗi GMM mà còn phải gia tăng cả hàm lượng gen trong các quần thể muỗi, thực hiện đầy đủ khâu kiểm chứng trong phòng thí nghiệm, chuẩn bị đầy đủ những tiền đề quan trọng trước khi đưa muỗi vào môi trường, hạn chế thấp nhất khả năng cạnh tranh của muỗi GMM do phải gồng lên gánh chịu quá sức về khả năng miễn dịch ngay chính trong cơ thể của nó.